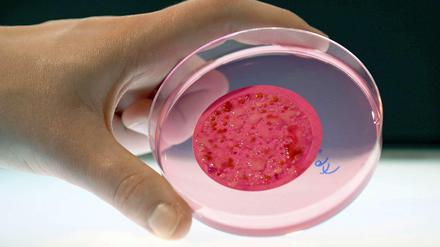

Severin Freund hat beim letzten Skisprung-Weltcup der Saison in Planica den zweiten Platz belegt.
Alle Tagesspiegel-Artikel vom 23.03.2014 – Seite 2
Für die Wimbledon-Finalistin 2013, Sabine Lisicki, läuft die Tennis-Saison 2014 bislang ernüchternd.

Der Kapitän geht bald von Bord: Sebastian Kehl verlängert seinen Vertrag bei Borussia Dortmund noch um ein Jahr und will dann aufhören, Fußball zu spielen. "Ich freue mich auf mein letztes Jahr in der Bundesliga", sagt der 34-Jährige.

Der Clasico zwischen Real Madrid und FC Barcelona ist auch ein Trainerduell. Carlo Ancelotti wird bei Real gefeiert, Gerardo Martino ist bei Barca fast schon gefeuert.

Die IG Metall hatte große Pläne mit Oliver Burkhard. Doch nun ist er Personalvorstand des Stahlkonzerns Thyssen-Krupp - und verantwortlich für 150 000 Mitarbeiter weltweit.

Der 1. FC Union verspielt erneut eine Führung – bleibt aber im Aufstiegsrennen. Doch die Nackenschläge häufen sich. "Schwer zu sagen, ab wann die ihre Spuren hinterlassen", sagt Trainer Uwe Neuhaus, "bisher ist das nicht der Fall".

Gaito Gasdanows traumhafter Debütroman „Ein Abend bei Claire“ erschien 1930 in einem russischen Exilverlag in Paris. Jetzt ist das Meisterwerk erstmals ins Deutsche übersetzt worden.

Hannover 96 ist gegen Borussia Dortmund keineswegs das schlechtere Team – und verliert dennoch mit 0:3. "Wir haben das sehr souverän zu Ende gebracht", sagt Trainer Jürgen Klopp, der wieder unter besonderer Beobachtung stand.

Zuerst Xavier Naidoo und BossHoss, nun Nena. Die Sängerin will sich wieder mehr um ihre Musik und zwei Bücher kümmern. ProSieben und Sat1 müssen nun ein weiteres Jurymitglied ersetzen.

Die Ministerpräsidenten der Länder hatten die Senkung der Rundfunkgebühren auf 17,50 Euro monatlich für Anfang 2015 angekündigt. Weil in einigen Bundesländer Wahlen anstehen, ist dieser Termin kaum zu halten.

Journalismus zwischen Anmaßung und Mut: Stephan Weichert, Gründungsmitglied des Debattenportals Vocer.org, ordnet die Medienwoche ein.

Zuerst Xavier Naidoo und BossHoss, nun Nena. Die Sängerin will sich wieder mehr um ihre Musik und zwei Bücher kümmern. ProSieben und Sat1 müssen nun ein weiteres Jurymitglied ersetzen.

Der FC Bayern München gewinnt 2:0 beim FSV Mainz 05 – den Meistertitel können die Münchner nun aber frühestens am Dienstag im Berliner Olympiastadion gegen Hertha BSC gewinnen.

Die Ministerpräsidenten der Länder hatten die Senkung der Rundfunkgebühren auf 17,50 Euro monatlich für Anfang 2015 angekündigt. Weil in einigen Bundesländer Wahlen anstehen, ist dieser Termin kaum zu halten.

Deutliche Entscheidung im Bruderduell: Raffael gewinnt mit Borussia Mönchengladbach gegen Hertha BSC und Ronny – und trifft zum entscheidenden 3:0. Die Gladbacher springen damit auf den fünften Tabellenplatz, der am Ende zur Europa-League-Teilnahme berechtigen würde.

Osteuropäer bremsen wegen der Abhängigkeit ihrer Volkswirtschaften von der Kohle, obwohl sie gleichzeitig vor der Abhängigkeit von Russland warnen. Umweltverbände kritisieren, dass die Vorschläge der EU-Kommission nicht ausreichen, um den Treibhausgasausstoß bis 2050 um 80 bis 95 Prozent zu senken.

Der Dokumentarfilm „Journey To Jah“ begleitet Gentleman und Alborosie nach Jamaika, wo die beiden Reggae-Sänger ihre Seelenheimat gefunden haben - und sehr erfolgreich sind.

Hochschulmedizinische Verbände zweifeln an der Qualität der schnellen Arztausbildung, die neue Medical Schools in Deutschland anbieten. Deren Niveau drohe deutlich unter dem an Universitätsklinika zu liegen.

Zuerst Xavier Naidoo und BossHoss, nun Nena. Die Sängerin will sich wieder mehr um ihre Musik und zwei Bücher kümmern. ProSieben und Sat1 müssen nun ein weiteres Jurymitglied ersetzen.

Derzeit läuft in der Station am Gleisdreieck in Kreuzberg die Berliner Fahrradschau. Die Messe zeigt die ganze kulturelle Vielfalt des Themas Fahrrad.

Wie ein Konzert der Rolling Stones in der Berliner Waldbühne zum maßlosen Exzess wurde. Aber das Leben ist weitergegangen und so auch die Stones. Helmut Schümann zieht Bilanz.

Die Nebeneinkünfte der Bundestagsabgeordneten sind jetzt öffentlich – und ein Brandenburger SPD-Politiker liegt dabei weit vorn. Allerdings freuen sich wohl andere über seine Zusatzeinnahmen bei großen Firmen.

Der Flohmarkt an der Straße des 17. Juni feiert seinen 40. Geburtstag. Lesen Sie hier Anekdoten von Tagesspiegel-Redakteuren über eine Ur-Berliner Emaille-Brotschale, ein ganz besonderes Fotoalbum, einen viel zu großen Schrank - und die Tricks eines Verkäufers.

Den weitgehend friedlichen Autonomen-Aufzügen in Kreuzberg und Moabit folgte eine ruhige Nacht. Die Polizei war mit mehreren Hundertschaften im Einsatz.

In Berlin paart sich eine Jogginghosen-Mentalität, die schon Thilo Sarrazin diagnostizierte, mit Ehrgeizlosigkeit. An Klaus Wowereit lässt sich die altneue Leidenschaft, möglichst unauffällig den Stillstand zu verwalten, gut ablesen.

Ein Mietwagen von Robben & Wientjes ist am frühen Sonntagmorgen auf dem Gelände der Autoverleih-Firma in Kreuzberg in Flammen aufgegangen. Das Feuer griff auf weitere Fahrzeuge über.

"Ein echter Kracher! 100 Tage Große Koalition" lautet der Titel des Talks im Tipi bei dem Tagesspiegel-Chefredakteur Lorenz Maroldt mit Brigitte Fehrle (Berliner Zeitung), Bettina Gaus (taz), Hajo Schumacher (Berliner Morgenpost) und Nikolaus Blome (Spiegel) diskutiert. Video-Livestream ab 12 Uhr hier.

In drei Jahren kann man sich zum Maßschneider qualifizieren. Die Ausbildung kann man schulisch oder dual absolvieren.

Frederick Douglass ist Sklave – und kennt nicht einmal den Tag seiner Geburt. Er wird zum berühmtesten Schwarzen des 19. Jahrhunderts und berät den US-Präsidenten. Nun lässt ihn der Bestsellerautor Colum McCann als Romanfigur aufleben.
Je nach Beruf und Qualifikation hat man die Wahl. Drei Beispiele

Die Autorin Sibylle Lewitscharoff nannte In-Vitro-Kinder „Halbwesen“. Hier antwortet ihr eine Mutter – und erzählt von Verzweiflung und Tortur.
Bekommen Mitarbeiter einen Tag frei, wenn sie an einem Feiertag arbeiten müssen? Diese Frage beantwortet die Arbeitsrechtlerin Anja Mengel.
Biotechnologie, Medizintechnik, Pharma: Absolventen im Bereich Life Sciences haben in der Hauptstadtregion gute Aussichten.

Was man über die Pflanze, die Wirkung und die Folgen wissen sollte.

Recht ist gut, wenn es berechenbar ist. Insofern haben die Bürger Bushido und Wowereit in ihrem privaten Händel gutes Recht bekommen. Juristisch war an der Anklage nichts dran

Einmal in der Woche fragen Sie Elisabeth Binder, wie man mit komplizierten oder peinlichen Situationen so umgeht, dass es am Ende keine Verstimmungen gibt: So kann's gehen..

Die beste Flüchtlingspolitik ist die Vermeidung von erzwungener Wanderung. Aber wie und wo arbeitet Europa daran, Entwicklungs- mit Wirtschafts- und Außenpolitik zusammenzudenken?
Warum Männer sich häufig zu wenig um ihre Gesundheit kümmern

Geringeres Einkommen, unten auf der Karriereleiter, weniger Einfluss: Frauen kommen im Beruf oft schlechter weg als Männer. Doch das soll sich ändern – durch Business-Netzwerke.

Viele Berufe rund um die Gesundheit lernt man an Fachschulen, doch inzwischen gibt es auch Studiengänge. Wohin sie führen und für wen sie sich lohnen.

Journalismus zwischen Anmaßung und Mut: Stephan Weichert, Gründungsmitglied des Debattenportals Vocer.org, ordnet die Medienwoche ein.

Das Anfang 2013 eröffnete Luxushotel im Charlottenburger Zoofenster-Hochhaus hat die Gewinner eines Literaturwettbewerbs gekürt. Damit will das hauseigene „Romanische Café“ seinem Namen gerecht werden, der an einen berühmten alten Künstlertreff erinnert.

Der US-Bundesstaat Colorado erlaubt den freien Verkauf von Marihuana in kleinen Mengen. Die Drogen bringen Steuereinnahmen in Millionenhöhe.

Coworking Spaces spielen eine wichtige Rolle im Ökosystem der Start-ups. Warum Entrepreneurs, die Seite an Seite im gemieteten Großraumbüro tüfteln, so erfolgreich sind.

Die aktuelle Bartmode bedeutet haarige Zeiten für die Hersteller von Rasierklingen wie Gillette und Wilkinson. Sie reagieren mit neuen Produkten.